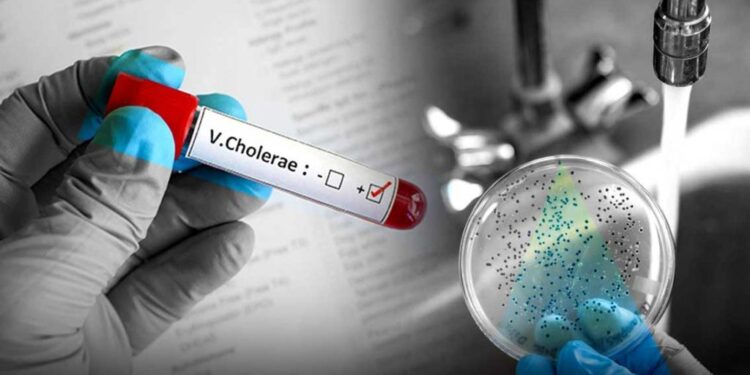

El Ministerio de Salud Pública (MSP) reportó la noche de este viernes un total de 16 casos positivos a cólera en la provincia Barahona. 14 de ellos de nacionalidad haitiana y dos dominicanos.
En un comunicado, el Ministerio dijo que hasta el momento 45 pacientes con cuadro diarreico, han sido atendidos en el Hospital Jaime Mota y las UNAP de Bahoruco y La Ciénega. Se les tomaron las muestras y fueron enviadas al Laboratorio Nacional doctor Defillo.
Dentro de los casos reportados, los pacientes poseen las siguientes comorbilidades: Hipertensión, Diabetes, Hepatitis C, Neumonía, Insuficiencia Renal Crónica y VIH, por lo cual ha motivado la permanencia de algunos de ellos en el hospital, según las autoridades.
El MSP reconoció el brote diarreico agudo que está afectando a moradores de la Ciénega y dijo que trabaja para controlarlo.
Fueron realizados operativos e intervenciones, en los cuales se han aplicado; además 4,457, kit con cloro líquido y en pasta para purificar agua, 2,090 colocación de suero de rehidratación oral, incluyendo 2,933 profilaxis (Doxiciclina de 100 GM).
“Los resultados de laboratorio de las diferentes fuentes acuíferas de los ríos Bahoruco y la Palmita, obtuvo resultados positivos a Coliformes fecales, E. coli, Pseudomonas, pero Negativo a Vibri cólera. Sin embargo, recomendamos ante la contaminación existente no consumir el agua de estos ríos”, explicaron las autoridades.
Muertes por brote de cólera
El comunicado de Salud Pública fue emitido luego de que el senador de Barahona, José del Castillo, reiterara la noche de hoy su llamado a las autoridades sanitarias a que acudan de manera urgente en auxilio de los habitantes de La Ciénega, Barahona, ante el incremento de la mortalidad por el brote de diarrea.
El legislador sureño afirmó que el cólera ya ha cobrado la vida de al menos 13 personas residentes en barrios y sectores de esa comunidad.
Sin embargo, Salud Pública no reportó muertes por la enfermedad.